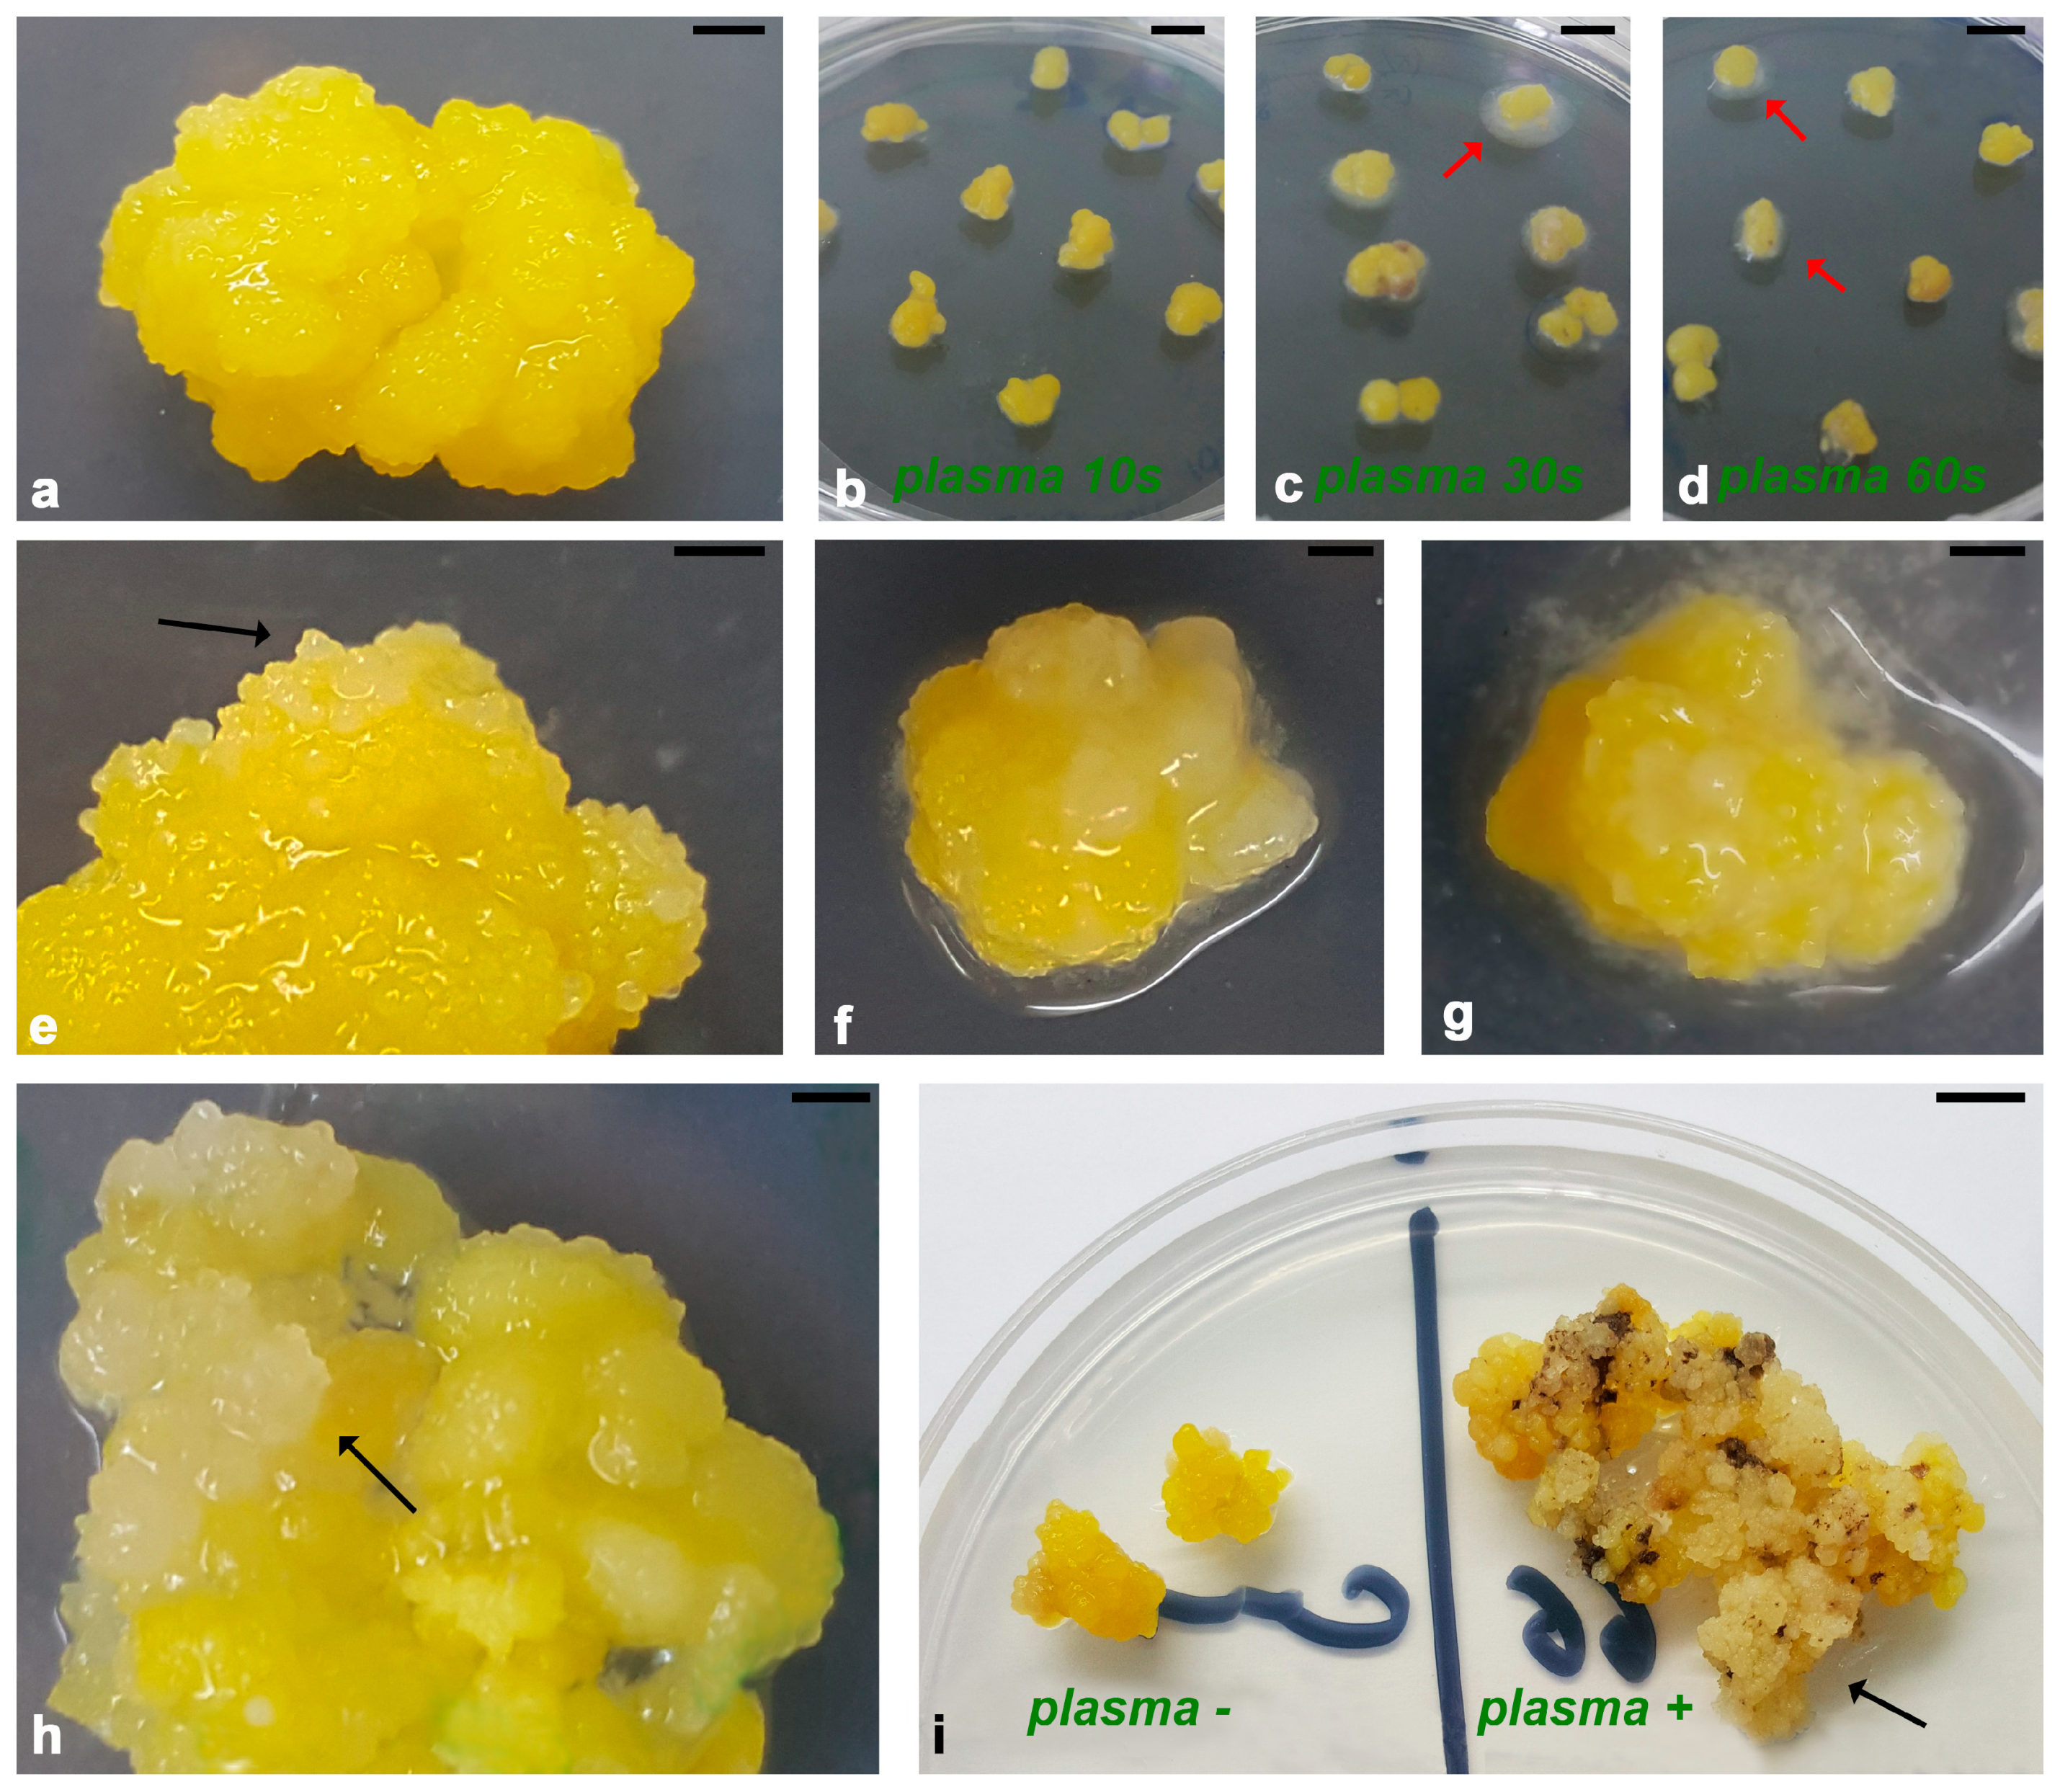
Horticulturae 11 00781 g003

Cold Plasma Treatment Alters the Morphology, Oxidative Stress Response and Specialized Metabolite Content in Yellow Iris (I. reichenbachii) Callus
Abstract
1. Introduction
2. Materials and Methods
2.1. Plant Material and Growth Conditions
2.2. Non-Thermal Plasma System and Treatment Conditions
2.3. Histological Analysis
2.4. Histochemical Localization of O2− and Production of H2O2
2.5. Protein Extraction
2.5.1. Native-PAGE Electrophoresis and Determination of Enzyme Activity
2.5.2. SDS-PAGE Electrophoresis and Immunoblotting
2.6. Preparation of the Extracts
2.7. UHPLC-LTQ Orbitrap MS Analysis
2.8. Statistical Analysis
3. Results
3.1. Morphological Changes in Iris Calli After Plasma Treatment
3.2. Histological Study of Iris Callus After PLASMA Treatment
3.3. Oxidative Stress Response of Iris Calli to Plasma Treatment
3.3.1. Histochemical Localization of O2− Production and H2O2 Accumulation in Iris Calli After Plasma Treatment
3.3.2. Activity of Antioxidant Enzymes in Iris Calli After Plasma Treatment
3.3.3. Immunoblot Analysis of Antioxidant Enzymes in Iris Calli After Plasma Treatment
3.4. Secondary Metabolite Profile of Iris Calli Before and After Plasma Treatment
4. Discussion
5. Conclusions
Supplementary Materials
Author Contributions
Funding
Data Availability Statement
Conflicts of Interest
Abbreviations
| CP | Cold Plasma |
| RF | Radio Frequency |
| ROS | Reactive Oxygen Species |
| RONS | Reactive Oxygen and Nitrogen Species |
| SOD | Superoxide Dismutase |
| MnSOD | Manganese Superoxide Dismutase |
| CuZnSOD | Copper Zink Superoxide Dismutase |
| CAT | Catalase |
| POX | Peroxidase |
| NAA | Naphthylacetic Acid |
| 2,4-D | 2,4-Dichlorophenoxyacetic Acid |
| EC | Embryogenic Callus |
| NEC | Non-Embryogenic Callus |
| OC | Organogenic Callus |
| NBT | Nitro Blue Tetrazolium |
| DAB | 3,3′-Diaminobenzidine |
| PCs | Parenchymatous Cells |
| MCs | Meristematic Centers |
References
- Veerana, M.; Mumtaz, S.; Rana, J.N.; Javed, R.; Panngom, K.; Ahmed, B.; Akter, K.; Choi, E.H. Recent Advances in Non-Thermal Plasma for Seed Germination, Plant Growth, and Secondary Metabolite Synthesis: A Promising Frontier for Sustainable Agriculture. Plasma Chem. Plasma Process. 2024, 44, 2263–2302. [Google Scholar] [CrossRef]
- Bruggeman, P.J.; Iza, F.; Brandenburg, R. Foundations of atmospheric pressure non-equilibrium plasmas. Plasma Sources Sci. Technol. 2017, 26, 123002. [Google Scholar] [CrossRef]
- Brandenburg, W.R.; Weltmann, K.-D. Atmospheric pressure plasma jets: An overview of devices and new directions. Plasma Sources Sci. Technol. 2015, 24, 064001. [Google Scholar] [CrossRef]
- Park, G.Y.; Park, S.J.; Choi, M.Y.; Koo, I.G.; Byun, J.H.; Hong, J.W.; Sim, J.Y.; Collins, G.J.; Lee, J.K. Atmospheric-pressure plasma sources for biomedical applications. Plasma Sources Sci. Technol. 2012, 21, 043001. [Google Scholar] [CrossRef]
- Fridman, A. Introduction to Theoretical and Applied Plasma Chemistry. In Plasma Chemistry; Cambridge University Press: Cambridge, UK, 2008; pp. 1–11. [Google Scholar] [CrossRef]
- Bradu, C.; Kutasi, K.; Magureanu, M.; Puač, N.; Živković, S. Reactive nitrogen species in plasma-activated water: Generation, chemistry and application in agriculture. J. Phys. D Appl. Phys. 2020, 53, 223001. [Google Scholar] [CrossRef]
- Bilea, F.; Garcia-Vaquero, M.; Magureanu, M.; Mihaila, I.; Mildažienė, V.; Mozetič, M.; Pawłat, J.; Primc, G.; Puač, N.; Robert, E.; et al. Non-Thermal Plasma as Environmentally-Friendly Technology for Agriculture: A Review and Roadmap. Crit. Rev. Plant Sci. 2024, 43, 428–486. [Google Scholar] [CrossRef]
- Domonkos, M.; Tichá, P.; Trejbal, J.; Demo, P. Applications of Cold Atmospheric Pressure Plasma Technology in Medicine, Agriculture and Food Industry. Appl. Sci. 2021, 11, 4809. [Google Scholar] [CrossRef]
- Puač, N.; Gherardi, M.; Shiratani, M. Plasma and agriculture. Plasma Process Polym. 2017, e1700174. [Google Scholar] [CrossRef]
- Tardast, Z.; Iranbakhsh, A.; Ebadi, M.; Oraghi Ardebili, Z. Corona discharge plasma stimulated production of atropine in callus of Datura inoxia by DNA hypomethylation and gene regulation: A novel technology for plant cell and tissue culture. Protoplasma 2023, 260, 1515–1525. [Google Scholar] [CrossRef]
- Puač, N.; Škoro, N.; Spasić, K.; Živković, S.; Milutinović, M.; Malović, G.; Petrović, Z.L. Activity of catalase enzyme in Paulownia tomentosa seeds during the process of germination after treatments with low pressure plasma and plasma activated water. Plasma Process Polym. 2018, 15, e1700082. [Google Scholar] [CrossRef]
- Bormashenko, E.; Grynyov, R.; Bormashenko, Y.; Drori, E. Cold radiofrequency plasma treatment modifies wettability and germination speed of plant seeds. Sci. Rep. 2012, 2, 741. [Google Scholar] [CrossRef] [PubMed]
- Sivachandiran, L.; Khacef, A. Enhanced seed germination and plant growth by atmospheric pressure cold air plasma: Combined effect of seed and water treatment. RSC Adv. 2017, 7, 1822–1832. [Google Scholar] [CrossRef]
- Lo Porto, C.; Ziuzina, D.; Los, A.; Boehm, D.; Palumbo, F.; Favia, P.; Tiwari, B.; Bourke, P.; Cullen, P.J. Plasma activated water and airborne ultrasound treatments for enhanced germination and growth of soybean. Innov. Food Sci. Emerg. 2018, 49, 13–19. [Google Scholar] [CrossRef]
- Waskow, A.; Howling, A.; Furno, I. Mechanisms of Plasma-Seed Treatments as a Potential Seed Processing Technology. Front. Phys. 2021, 9, 617345. [Google Scholar] [CrossRef]
- Ito, M.; Oh, J.-S.; Ohta, T.; Shiratani, M.; Hori, M. Current status and future prospects of agricultural applications using atmospheric-pressure plasma technologies. Plasma Process Polym. 2018, 15, 1700073. [Google Scholar] [CrossRef]
- Gierczik, K.; Vukušić, T.; Kovács, L.; Székely, A.; Szalai, G.; Milošević, S.; Kocsy, G.; Kutasi, K.; Galiba, G. Plasma-activated water to improve the stress tolerance of barley. Plasma Process Polym. 2020, 17, 1900123. [Google Scholar] [CrossRef]
- Mildaziene, V.; Ivankov, A.; Pauzaite, G.; Naucienė, Z.; Zukiene, R.; Degutyte-Fomins, L.; Pukalskas, A.; Rimantas Venskutonis, P.; Filatova, I.; Lyushkevichet, V. Seed treatment with cold plasma and electromagnetic field induces changes in red clover root growth dynamics, flavonoid exudation, and activates nodulation. Plasma Process Polym. 2021, 18, 2000160. [Google Scholar] [CrossRef]
- Lee, H.; Kim, J.E.; Chung, M.-S.; Min, S.C. Cold plasma treatment for the microbiological safety of cabbage, lettuce, and dried figs. Food Microbiol. 2015, 51, 74–80. [Google Scholar] [CrossRef]
- Filatova, I.I.; Lyushkevich, V.A.; Kalatskaja, J.N.; Goncharik, S.V.; Mildaziene, V.; Pauzaite, G. Influence of plasma and radiowave treatment of seeds on the accumulation of some secondary metabolites in plants. In Proceedings of the 29 Summer School and International Symposium on the Physics of Ionized Gases; SPIG 2018, Contributed Papers & Abstracts of Invited Lectures, Topical Invited Lectures, Progress Reports and Workshop Lectures, Belgrade, Serbia, 28 August–1 September 2018; Poparić, G., Obradović, B., Borka, D., Rajković, M., Eds.; Vinča Institute of Nuclear Sciences, University of Belgrade: Belgrade, Serbia, 2018; pp. 234–237. [Google Scholar]
- Yodpitak, S.; Mahatheeranont, S.; Boonyawan, D.; Sookwong, P.; Roytrakul, S.; Norkaew, O. Cold plasma treatment to improve germination and enhance the bioactive phytochemical content of germinated brown rice. Food Chem. 2019, 289, 328–339. [Google Scholar] [CrossRef]
- Judickaitė, A.; Venckus, J.; Koga, K.; Shiratani, M.; Mildažienė, V.; Žūkienė, R. Cold Plasma-Induced Changes in Stevia rebaudiana Morphometric and Biochemical Parameter Correlations. Plants 2023, 12, 1585. [Google Scholar] [CrossRef]
- Singh, H.; Niharika; Lamichhane, P.; Gupta, R.; Kaushik, N.; Choi, E.H.; Kaushik, N.K. Enhancing crop health and sustainability: Exploring the potential of secondary metabolites and non-thermal plasma treatment as alternatives to pesticides. Plant Biotechol. Rep. 2023, 17, 803–820. [Google Scholar] [CrossRef]
- Puač, N.; Petrović, Z.L.; Malović, G.; Đorđević, A.; Živković, S.; Giba, Z.; Grubišić, D. Measurements of voltage–current characteristics of a plasma needle and its effect on plant cells. J. Phys. D Appl. Phys. 2006, 39, 3514–3519. [Google Scholar] [CrossRef]
- Puač, N.; Živković, S.; Selaković, N.; Milutinović, M.; Boljević, J.; Malović, G.; Petrović, Z.L. Long and short term effects of plasma treatment on meristematic plant cells. Appl. Phys. Lett. 2014, 104, 214106. [Google Scholar] [CrossRef]
- Škoro, N.; Živković, S.; Jevremović, S.; Puač, N. Treatment of Chrysanthemum Synthetic Seeds by Air SDBD Plasma. Plants 2022, 11, 907. [Google Scholar] [CrossRef]
- Tsuboyama, S.; Okumura, T.; Attri, P.; Koga, K.; Shiratani, M.; Kuchitsu, K. Growth control of Marchantia polymorpha gemmae using nonthermal plasma irradiation. Sci. Rep. 2024, 14, 3172. [Google Scholar] [CrossRef]
- Yanagawa, Y.; Suenaga, Y.; Iijima, Y.; Endo, M.; Sanada, N.; Katoh, E.; Toki, S.; Okino, A.; Mitsuhara, I. Genome editing by introduction of Cas9/sgRNA into plant cells using temperature-controlled atmospheric pressure plasma. PLoS ONE 2023, 18, e0281767. [Google Scholar] [CrossRef]
- Ozyigit, I.I.; Dogan, I.; Hocaoglu-Ozyigit, A.; Yalcin, B.; Erdogan, A.; Yalcin, I.E.; Cabi, E.; Kaya, Y. Production of secondary metabolites using tissue culture-based biotechnological applications. Front. Plant Sci. 2023, 14, 1132555. [Google Scholar] [CrossRef]
- De Bellis, R.; Chiarantini, L.; Potenza, L.; Gorassini, A.; Verardo, G.; De Marco, R.; Benayada, L.; Stocchi, V.; Albertini, M.C.; Fraternale, D. High production of secondary metabolites and biological activities of Cydonia oblonga Mill. pulp fruit callus. J. Funct. Foods 2022, 94, 105133. [Google Scholar] [CrossRef]
- Ozden, M. Secondary metabolite production in callus cultures of Vitis vinifera: Influence of genotype and sucrose concentration in the medium on antioxidant activity. Acta Physiol. Plant 2024, 46, 6. [Google Scholar] [CrossRef]
- Lee, K.Y.; Nam, D.-H.; Jeon, Y.; Park, S.U.; Cho, J.; Gulandaz, M.A.; Chung, S.-O.; Lee, G.-J. Exploring the Production of Secondary Metabolites from a Halophyte Tetragonia tetragonoides through Callus Culture. Horticulturae 2024, 10, 244. [Google Scholar] [CrossRef]
- Maqbool, M.; Ishtiaq, M.; Mazhar, M.W.; Casini, R.; Mahmoud, E.A.; Elansary, H.O. Enhancing Bioactive Metabolite Production in Aerva sanguinolenta Callus Cultures through Silver Nanoparticle and Salicylic Acid Elicitation. Sustainability 2023, 15, 10395. [Google Scholar] [CrossRef]
- Darigh, F.; Iranbakhsh, A.; Oraghi Ardebili, Z.; Ebadi, M. 2022 Non-thermal plasma improved callogenesis performance and elicited the production of cannabinoids by modifying DNA methylome, expression of WRKY1 and ERF1B transcription factors, and expression of genes that contributed to the biosynthesis of cannabinoids. Protoplasma 2023, 260, 159–170. [Google Scholar] [CrossRef] [PubMed]
- Kaššák, P. Secondary metabolites of the choosen genus Iris species. Acta Univ. Agric. Silvic. Mendel. Brun. 2012, 60, 269–280. [Google Scholar] [CrossRef]
- Hoang, L.; Beneš, F.; Fenclová, M.; Kronusová, O.; Švarcová, V.; Řehořová, K.; Baldassarre Švecová, E.; Vosátka, M.; Hajšlová, J.; Kaštánek, P.; et al. Phytochemical Composition and In Vitro Biological Activity of Iris spp. (Iridaceae): A New Source of Bioactive Constituents for the Inhibition of Oral Bacterial Biofilms. Antibiotics 2020, 9, 403. [Google Scholar] [CrossRef]
- Öztaş, F.; Türkmen, A.; Öztaş, H.; Türkmen, M. The Medical Properties of Iris and its Usage in Pharmaceutical, Perfumery and Cosmetic Industries. In Medical Research and Its Applications; Veeramani, V.P., Ed.; BP International: New Delhi, India, 2024; Volume 4, pp. 114–124. [Google Scholar] [CrossRef]
- Khatib, S.; Faraloni, C.; Bouissane, L. Exploring the use of Iris species: Antioxidant properties, phytochemistry, medicinal andindustrial applications. Antioxidants 2022, 11, 526. [Google Scholar] [CrossRef]
- Kukula-Koch, W.; Sieniawska, E.; Widelski, J.; Urjin, O.; Głowniak, P.; Skalicka Woźniak, K. Major secondary metabolites of Iris spp. Phytochem. Rev. 2015, 14, 51–80. [Google Scholar] [CrossRef]
- Mizuno, T.; Okuyama, Y.; Iwashina, T. Phenolic compounds from Iris rossii, and their chemotaxonomic and systematic significance. Biochem. System Ecol. 2012, 44, 157–160. [Google Scholar] [CrossRef]
- Kostić, A.Ž.; Gašić, U.M.; Pešić, M.B.; Stanojević, S.P.; Barać, M.B.; Mačukanović-Jocić, M.P.; Avramov, S.N.; Tešić, Ž.L. Phytochemical Analysis and Total Antioxidant Capacity of Rhizome, Above-Ground Vegetative Parts and Flower of Three Iris Species. Chem. Biodivers. 2019, 16, e1800565. [Google Scholar] [CrossRef]
- Mykhailenko, O.; Gudžinskas, Z.; Kovalyov, V.; Desenko, V.; Ivanauskas, L.; Bezruk, I.; Georgiyants, V. Effect of ecological factors on the accumulation of phenolic compounds in Iris species from Latvia, Lithuania and Ukraine. Phytochem. Anal. 2020, 31, 545–563. [Google Scholar] [CrossRef]
- Schütz, C.; Quitschau, M.; Hamburger, M.; Potterat, O. Profiling of isoflavonoids in Iris germanica rhizome extracts by microprobe NMR and HPLC-PDA-MS analysis. Fitoterapia 2011, 82, 1021–1026. [Google Scholar] [CrossRef]
- Iwashina, T.; Mizuno, T. Flavonoids and Xanthones from the genus Iris: Phytochemistry, relationships with flower colors and taxonomy, and activities and function. Nat. Prod. Commun. 2020, 15. [Google Scholar] [CrossRef]
- Xie, G.Y.; Zhu, Y.; Shu, P.; Qin, X.Y.; Wu, G.; Wang, Q.; Qin, M.J. Phenolic metabolite profiles and antioxidants assay of three Iridaceae medicinal plants for traditional Chinese medicine “She-gan” by on-line HPLC-DAD coupled with chemiluminescence (CL) and ESI-Q-TOF-MS/MS. J. Pharm. Biomed. Anal. 2014, 98, 40–51. [Google Scholar] [CrossRef] [PubMed]
- Mykhailenko, O.; Korinek, M.; Ivanauskas, L.; Bezruk, I.; Myhal, A.; Petrikaitė, V.; El-Shazly, M.; Lin, G.-H.; Lin, C.-Y.; Yen, C.-H.; et al. Qualitative and Quantitative Analysis of Ukrainian Iris Species: A Fresh Look on Their Antioxidant Content and Biological Activities. Molecules 2020, 25, 4588. [Google Scholar] [CrossRef] [PubMed]
- Reshi, Z.A.; Ahmad, W.; Lukatkin, A.S.; Javed, S.B. From Nature to Lab: A Review of Secondary Metabolite Biosynthetic Pathways, Environmental Influences, and In Vitro Approaches. Metabolites 2023, 13, 895. [Google Scholar] [CrossRef]
- Ascough, G.D.; Erwin, J.E.; Van Staden, J. Micropropagation of iridace-A review. Plant Cell Tissue Organ. Cult. 2009, 97, 1–19. [Google Scholar] [CrossRef]
- Al-Gabbiesh, A.; Hassawi, D.S.; Afifi, F.U. In vitro propagation of endagared Iris species. J. Biol. Sci. 2006, 6, 1035–1040. [Google Scholar] [CrossRef]
- Bae, K.; Yoo, K.; Lee, H.; Yoon, E. Callus induction and plant regeneration of Iris dichotoma Pall. in endangered species. J. Plant Biotechnol. 2012, 39, 182–188. [Google Scholar] [CrossRef]
- Safari, N.; Tehranifar, A.; Kharrazi, M.; Shoor, M. Micropropagation of endangered Iris Ferdowsii Joharchi & Memariani through callus induction. Plant Cell Tissue Organ. Cult. 2023, 154, 595–604. [Google Scholar] [CrossRef]
- Wang, Y.; Jeknic, Z.; Ernst, R.C.; Chen, T.H.H. Efficient plant regeneration from suspension-cultured cells of tall bearded iris. HortScience 1999, 34, 730–735. [Google Scholar] [CrossRef]
- Yabuya, T.; Ikeda, Y.; Adachi, T. In vitro propagation of Japanese garden Iris, Iris ensata Thunb. Euphytica 1991, 57, 77–81. [Google Scholar] [CrossRef]
- Laublin, G.; Saini, H.S.; Cappadocia, M. In vitro plant regeneration via somatic embryogenesis from root culture of some rhizomatous irises. Plant Cell Tissue Organ. Cult. 1991, 27, 21–27. [Google Scholar] [CrossRef]
- Liu, H.; Fan, L.; Song, H.; Tang, B.; Wang, L. Establishment of regeneration system of callus pathway for Iris sanguinea Donn ex Horn. Vitr. Cell Dev. Biol. Plant 2020, 56, 694–702. [Google Scholar] [CrossRef]
- Gozu, Y.; Yokoyama, M.; Nakamura, M.; Namba, R.; Yomogida, K.; Yanagi, M.; Nakamura, S. In vitro propagation of Iris pallida. Plant Cell Rep. 1993, 13, 12–16. [Google Scholar] [CrossRef] [PubMed]
- Jehan, H.; Courtois, D.; Ehret, C.; Lerch, K.; Petiard, V. Plant regeneration of Iris pallida Lam. and Iris germanica L. via somatic embryogenesis from leaves, apices and young flowers. Plant Cell Rep. 1994, 13, 671–675. [Google Scholar] [CrossRef]
- Shimizu, K.; Nagaike, H.; Yabuya, T.; Adachi, T. Plant regeneration from suspension culture of Iris germanica L. Plant Cell Tissue Organ. Cult. 1997, 50, 27–31. [Google Scholar] [CrossRef]
- Meucci, A.; Ghelardi, C.; Maggini, R.; Malorgio, F.; Chietera, G.; Mensuali, A. Micropropagation via somatic embryogenesis of Iris pallida Lam. Ecotypes. Plant Cell, Tissue Organ Cult (PCTOC) 2024, 158, 21. [Google Scholar] [CrossRef]
- Boltenkov, E.V.; Rybin, V.G.; Zarembo, E.V. Cultivation of Iris ensata Thunb. callus tissue. Prikl. Biokhimiia Mikrobiol. 2004, 40, 244–251. [Google Scholar]
- Boltenkov, E.V.; Zarembo, E.V. In vitro regeneration and callogenesis in tissue culture of floral organs of the genus Iris (Iridaceae). Izv. Akad. Nauk. Ser. Biol. 2005, 2, 174–179. [Google Scholar] [CrossRef]
- Akashi, T.; Ishizaki, M.; Aoki, T.; Ayabe, S.-I. Isoflavonoid production by adventitious root cultures of Iris germanica (Iridaceae). Plant Biotechnol. 2005, 22, 207–215. [Google Scholar] [CrossRef]
- Karpitskiy, D.A.; Bessonova, E.A.; Kartsova, L.A.; Tikhomirova, L.I. Development of approach for flavonoid profiling of biotechnological raw materials Iris sibirica L. by HPLC with high-resolution tandem mass spectrometry. Phytochem. Anal. 2022, 33, 869–878. [Google Scholar] [CrossRef]
- Michalak, A.; Krauze-Baranowska, M.; Migas, P.; Kawiak, A.; Kokotkiewicz, A.; Królicka, A. Iris pseudacorus as an easily accessible source of antibacterial and cytotoxic compounds. J. Pharm. Biomed. Anal. 2021, 195, 113863. [Google Scholar] [CrossRef] [PubMed]
- Para, G.; Baratti, J. Irones and precursors synthesized by Iris sibirica tissue culture. Biosci. Biotechnol. Biochem. 1992, 56, 1132–1133. [Google Scholar] [CrossRef] [PubMed]
- Marner, F.J.; Simic, K.; Scholz, B.; Küster, B. Isolation and structure determination of new iridal from Iris sibirica. J. Nat. Prod. 1995, 58, 299–301. [Google Scholar] [CrossRef]
- Ritzdorf, I.; Bartels, M.; Kerp, B.; Kasel, T.; Klonowski, S.; Marner, F.J. Identification of 10-desoxyiridal as an intermediate in the biosynthesis of iridals. Phytochemistry 1999, 50, 995–1003. [Google Scholar] [CrossRef]
- Afifi, F.U.; Al-Gabbiesh, A.; Hassawi, D.S. Essential Oil Production from the Callus of Threatened Iris Species of Jordan. In Floriculture, Ornamental, and Plant Biotechnology; Global Science Books: London, UK, 2008; Volume V, pp. 227–233. [Google Scholar]
- Jevremović, S.; Kristić-Milosević, D.; De Carlo, A.; Benelli, K.; Lambardi, M.; Antonić, D.; Trifunović Momchilov, M.; Lojić, M.; Subotić, A. Kultura tkiva i krioprezervacija kao metode za povećanje produkcije mangiferina kod balkanske perunike (Iris reichenbachii Heuffel). In Proceedings of the Zbornik radova: III Simpozijum biologa i ekologa Republike Srpske, Banja Luka, Republika Srpska, 12–14 November 2016; Golub, D., Ed.; Prirodno-matematički fakultet, Univerzitet u Banja Luci: Banja Luka, Republika Srpska, 2016; pp. 41–53. [Google Scholar]
- Tarbeeva, D.V.; Fedoreyev, S.A.; Veselova, M.V.; Kalinovskiy, A.I.; Seletskaya, L.D.; Mazurok, T.I.; Bulgakov, V.P. Polyphenolic compounds from callus cultures of Iris pseudacorus. Nat. Prod. Commun. 2013, 8, 1419–1420. [Google Scholar] [CrossRef]
- Zhu, Y.; Chen, Y.; Zhang, X.; Xie, G.Y.; Qin, M.J. Copper stress-induced changes in biomass accumulation, antioxidant activity and flavonoid contents in Belamcanda chinensis calli. Plant Cell Tissue Organ. Cult. 2020, 142, 299–311. [Google Scholar] [CrossRef]
- Michalak, A.; Królicka, A. The influence of elicitors for total phenolic content in tissues of Iris pseudacorus plants cultured in vitro. In Proceedings of the XI Conference “In Vitro Cultures In Biotechnology and Plant Physiology”, Kraków, Poland, 4–6 December 2019; Volume 61, Suppl 1. p. 57. [Google Scholar]
- Jeknić, Z.; Jeknić, S.; Jevremović, S.; Subotić, A.; Chen, T.H.H. Alteration of flower color in Iris germanica L. ‘Fire Bride’ through ectopic expression of phytoene synthase gene (crtB) from Pantoea agglomerans. Plant Cell Rep. 2014, 33, 1307–1321. [Google Scholar] [CrossRef]
- Aslanyants, L.K.; Marshavina, Z.V. Volatile oil synthesized by Iris sibirica tissue cultures. Appl. Biochem. Microbiol. 1979, 15, 581–585. [Google Scholar]
- Mazko, O.N.; Tikhomirova, L.I.; Shcherbakova, L.V.; Bazarnova, N.G.; Karpitsky, D.A. Flavonoids of Iris sibirica L. grown in vitro culture. Khimiya Rastit. Syr’ya 2021, 3, 301–308. (In Russian) [Google Scholar] [CrossRef]
- Tikhomirova, L.I.; Ilyicheva, T.N. Preparation of biotechnological raw materials of Iris sibirica L. with a given content of mangiferin and antiviral activity. IOP Conf. Ser. Earth Environ. Sci. 2020, 421, 022049. [Google Scholar] [CrossRef]
- Jevremović, S.; Lojić, M.; Jeknić, Z.; Trifunović-Momčilov, M.; Antonić, D.; Petrić, M.; Subotić, A.; Radojević, L. In vitro propagation of Iris reichenbachii Heuff. and clonal fidelity of regenerated plants. Bot. Serb. 2015, 39, 129–136. [Google Scholar]
- Williams, C.A.; Harborne, J.B.; Goldblatt, P. Correlations between phenolic patterns and tribal classification in the family iridaceae. Phytochemistry 1986, 25, 2135–2154. [Google Scholar] [CrossRef]
- Williams, C.A.; Harborne, J.B.; Colasante, M. Flavonoid and xanthone patterns in bearded iris species and the pathway of chemical evolution in the genus. Biochem. System. Ecol. 1997, 25, 309–325. [Google Scholar] [CrossRef]
- Šavikin-Fodulović, K.; Stojanović, D.; Menković, N. Fitohemijska i anatomska analiza vrste Iris reichenbachii Heuff. Lek. Sirovine 2000, 20, 21–26. [Google Scholar]
- Šarıć Medıć, B.; Jerkovıć-Mujkıć, A.; Cubara, B.; Durmıć Pašıć, A.; Hanjalıć Kurtovıć, J.; Bajrovıć, K.; Omeragić, E.; Dedić, M.; Bogunić, F.; Pojskic, L. Crude Extracts of Three Iris Species as Sources of MRSA Antimicrobial Compounds. Eur. J. Biol. 2024, 83, 182–188. [Google Scholar] [CrossRef]
- Jevremović, S.; Subotić, A.; Radojević, L.J. In vitro morphogenesis of dwarf irises. In Floriculture, Ornamental and Plant Biotechnology: Advances and Topical Issues; Teixeira da Silva, J., Ed.; Global Science Books: London, UK, 2006; Volume II, pp. 551–557. [Google Scholar]
- Jevremović, S.; Jeknić, Z.; Subotić, A. Micropropagation of irises. In Protocols for Micropropagation of Selected Economically-Important Horticultural Plants. Methods in Molecular Biology; Lambardi, M., Ozudogru, E.A., Jain, S.M., Eds.; Humana Press-Springer: Totowa, NJ, USA, 2012; Volume 994, pp. 291–304. [Google Scholar] [CrossRef]
- Živković, S.; Jevremović, S.; Gašić, U.; Milutinović, M.; Petrović, Z.L.; Škoro, N.; Puač, N. Long term effects in dwarf bearded iris (Iris reichenbachii Heuff.) calli metabolism induced by plasma treatment. In Proceedings of the Book of Abstracts: 9th Central European Symposium on Plasma Chemistry (CESPC-9) Joint with COST Action CA19110 Plasma Applications for Smart and Sustainable Agriculture (PlAgri), Vysoké Tatry, Slovakia, 4–9 September 2022; Hensel, K., Cimerman, R., Lavrikova, A., Janda, M., Machala, Z., Eds.; FMFI UK: Bratislava, Slovakia, 2022; p. 137. [Google Scholar]
- Radojević, L.; Subotić, A. Plant regeneration of Iris setosa Pall. through somatic embryogenesis and organogenesis. J. Plant Physiol. 1992, 139, 690–696. [Google Scholar] [CrossRef]
- Kim, T.D.; Ahn, C.H.; Bae, K.H.; Choi, Y.E. The embryogenic competency and morphological changes during somatic embryogenesis in Iris pseudacorus. Plant Biotechnol. Rep. 2009, 3, 251–257. [Google Scholar] [CrossRef]
- Murashige, T.; Skoog, F. A revised medium for rapid growth and bioassay with tobacco tissue cultures. Physiol. Plant. 1962, 15, 473–497. [Google Scholar] [CrossRef]
- Puač, N.; Miletić, M.; Mojović, M.; Popović-Bijelić, A.; Vuković, D.; Miličić, B.; Maletić, D.; Lazović, S.; Malović, G.; Petrović, Z. Sterilization of bacteria suspensions and identification of radicals deposited during plasma treatment. Open Chem. 2015, 13, 000010151520150041. [Google Scholar] [CrossRef]
- Betekhtin, A.; Milewska-Hendel, A.; Chajec, L.; Rojek, M.; Nowak, K.; Kwasniewska, J.; Wolny, E.; Kurczynska, E.; Hasterok, R. 5-Azacitidine Induces Cell Death in a Tissue Culture of Brachypodium distachyon. Int. J. Mol. Sci. 2018, 19, 1806. [Google Scholar] [CrossRef]
- Jambunathan, N. Determination and Detection of Reactive Oxygen Species (ROS), Lipid Peroxidation, and Electrolyte Leakage in Plants. In Plant Stress Tolerance. Methods in Molecular Biology; Sunkar, R., Ed.; Humana Press: Totowa, NJ, USA, 2010; Volume 639, pp. 292–298. [Google Scholar] [CrossRef]
- Dmitrović, S.; Perišić, M.; Stojić, A.; Živković, S.; Boljević, J.; Živković, J.N.; Aničić, N.; Ristić, M.; Mišić, D. Essential oils of two Nepeta species inhibit growth and induce oxidative stress in ragweed (Ambrosia artemisiifolia L.) shoots in vitro. Acta physiol. Plant 2015, 37, 64. [Google Scholar] [CrossRef]
- Božunović, J.; Živković, S.; Gašić, U.; Glamočlija, J.; Ćirić, A.; Matekalo, D.; Šiler, B.; Soković, M.; Tešić, Ž.; Mišić, D. In vitro and in vivo transformations of Centaurium erythraea secoiridoid glucosides alternate their antioxidant and antimicrobial capacity. Ind. Crops Prod. 2018, 111, 705–721. [Google Scholar] [CrossRef]
- Banjanac, T.; Dragićević, M.; Šiler, B.; Gašić, U.; Bohanec, B.; Nestorović Živković, J.; Trifunović, S.; Mišić, D. Chemodiversity of two closely related tetraploid Centaurium species and their hexaploid hybrid: Metabolomic search for high-resolution taxonomic classifiers. Phytochemistry 2017, 140, 27–44. [Google Scholar] [CrossRef] [PubMed]
- Zhang, Y.Y.; Wang, Q.; Qi, L.W.; Qin, X.Y.; Qin, M.J. Characterization and determination of the major constituents in Belamcandae Rhizoma by HPLC–DAD–ESI-MSn. J. Pharm. Biomed. Anal. 2011, 56, 304–314. [Google Scholar] [CrossRef]
- Chen, D.; Meng, Y.; Zhu, Y.; Wu, G.; Yuan, J.; Qin, M.; Xie, G. Qualitative and quantitative analysis of C-glycosyl-flavones of iris lactea leaves by liquid chromatography/tandem mass spectrometry. Molecules 2018, 23, 3359. [Google Scholar] [CrossRef]
- Ibrahim, S.; Al-Ahdal, A.; Khedr, A.; Mohamed, G. Antioxidant α-amylase inhibitors flavonoids from Iris germanica rhizomes. Rev. Bras. De Farmacogn. 2017, 27, 170–174. [Google Scholar] [CrossRef]
- Yu, X.; Li, M.; O’Doherty, G.A. De novo symmetric approach to the disaccharide portion of SCH-47554. Heterocycles 2011, 82, 1577–1584. [Google Scholar] [CrossRef]
- Malović, G.; Puač, N.; Lazović, S.; Petrović, Z. Mass analysis of an atmospheric pressure plasma needle discharge. Plasma Sources Sci. Technol. 2010, 19, 034014. [Google Scholar] [CrossRef]
- Živković, S.; Jevremović, S.; Puač, N.; Škoro, N.; Petrović, Z.L. Morphological and physiological aspects of plasma treatment-induced changes in plant cells and tissues. In Proceedings of the XXIInd International Conference on Gas Discharges and their Applications, Novi Sad, Serbia, 2–7 September 2018; Petrović, Z.L., Puač, N., Dujko, S., Škoro, N., Eds.; Serbian Academy of Sciences and Arts: Belgrade, Serbia, 2018; pp. 646–649. [Google Scholar]
- Radojevic, L.; Landré, P. Cytological features of developing embryogenic callus and somatic embryos of Iris pumila L. and Iris setosa Pall. G. Bot. Ital. Off. J. Soc. Bot. Ital. 1995, 129, 1213–1224. [Google Scholar] [CrossRef]
- Stanišić, M.; Raspor, M.; Ninković, S.; Milošević, S.; Ćalić, D.; Bohanec, B.; Trifunović, M.; Petrić, M.; Subotić, A.; Jevremović, S. Clonal fidelity of Iris sibirica plants regenerated by somatic embryogenesis and organogenesis in leaf-base culture—RAPD and flow cytometer analyses. S. Afr. J. Bot. 2015, 96, 42–52. [Google Scholar] [CrossRef]
- Li, D.; Ji, C.; Shao, L.; Xu, T.; Chen, X.; Wang, X.; Zhang, R.; Cui, Y.; Zhang, J.; Xia, Y. An Efficient and Environmentally Friendly Strategy for Embryogenic Callus Induction and Plant Regeneration of Iris pseudacorus L. J. Plant Growth Regul. 2025. [Google Scholar] [CrossRef]
- Živković, S.; Jevremović, S.; Milutinović, M.; Puač, N.; Petrović, Z.L.; Škoro, N. Alteration in plant tissue morphology and physiology induced by plasma treatment. In Program Abstracts of the Twenty-First International Summer School on Vacuum, Electron and Ion Technologies (VEIT 2019); Heron Press: Birmingham, UK, 2019; pp. 63–64. [Google Scholar]
- Kurczynska, E.; Godel-Jedrychowska, K. Apoplastic and symplasmic markers of somatic embryogenesis. Plants 2023, 12, 1951. [Google Scholar] [CrossRef] [PubMed]
- Karimi, J.; Bansal, S.A.; Kumar, V.; Pasalari, H.; Badr, A.A.; Nejad, Z.J. Effect of cold plasma on plant physiological and biochemical processes: A review. Biologia 2024, 79, 3475–3487. [Google Scholar] [CrossRef]
- Adhikari, B.; Adhikari, M.; Park, G. The effects of plasma on plant growth, development, and sustainability. Appl. Sci. 2020, 10, 6045. [Google Scholar] [CrossRef]
- Priatama, R.A.; Pervitasari, A.N.; Park, S.; Park, S.J.; Lee, Y.K. Current Advancements in the Molecular Mechanism of Plasma Treatment for Seed Germination and Plant Growth. Int. J. Mol. Sci. 2022, 23, 4609. [Google Scholar] [CrossRef]
- Li, K.; Zhong, C.; Shi, Q.; Bi, H.; Gong, B. Cold plasma seed treatment improves chilling resistance of tomato plants through hydrogen peroxide and abscisic acid signaling pathway. Free Radic. Biol. Med. 2021, 172, 286–297. [Google Scholar] [CrossRef]
- Waszczak, C.; Carmody, M.; Kangasjärvi, J. Reactive oxygen species in plant signaling. Annu. Rev. Plant Biol. 2018, 69, 209–236. [Google Scholar] [CrossRef]
- Wang, H.; Zhang, Y.; Jiang, H.; Cao, J.; Jiang, W. A comprehensive review of effects of electrolyzed water and plasma-activated water on growth, chemical compositions, microbiological safety and postharvest quality of sprouts. Trends Food Sci. Technol. 2022, 129, 449–462. [Google Scholar] [CrossRef]
- Zahoranová, A.; Henselová, M.; Hudecová, D.; Kaliňáková, B.; Kováčik, D.; Medvecká, V.; Černák, M. Effect of cold atmospheric pressure plasma on the wheat seedlings vigor and on the inactivation of microorganisms on the seeds surface. Plasma Chem. Plasma Proc. 2016, 36, 397–414. [Google Scholar] [CrossRef]
- Hosseini, S.I.; Mohsenimehr, S.; Hadian, J.; Ghorbanpour, M.; Shokri, B. Physico-chemical induced modification of seed germination and early development in artichoke (Cynara scolymus L.) using low energy plasma technology. Phys. Plasmas 2018, 25, 013525. [Google Scholar] [CrossRef]
- Kostoláni, D.; Ndiffo Yemeli, G.B.; Švubová, R.; Kyzek, S.; Machala, Z. Physiological responses of young pea and barley seedlings to plasma-activated water. Plants 2021, 10, 1750. [Google Scholar] [CrossRef] [PubMed]
- Rahman, M.M.; Sajib, S.A.; Rahi, M.S.; Tahura, S.; Roy, N.C.; Parvez, S.; Reza, M.A.; Talukder, M.R.; Kabir, A.H. Mechanisms and signaling associated with LPDBD plasma mediated growth improvement in wheat. Sci. Rep. 2018, 8, 10498. [Google Scholar] [CrossRef] [PubMed]
- Cui, D.; Yin, Y.; Sun, H.; Wang, X.; Zhuang, J.; Wang, L.; Ma, R.; Jiao, Z. Regulation of cellular redox homeostasis in Arabidopsis thaliana seedling by atmospheric pressure cold plasma-generated reactive oxygen/nitrogen species. Ecotoxicol. Environ. Saf. 2022, 240, 113703. [Google Scholar] [CrossRef] [PubMed]
- Bailly, C.; Leymarie, J.; Lehner, A.; Rousseau, S.; Côme, D.; Corbineau, F. Catalase activity and expression in developing sunflower seeds as related to drying. J. Exp. Bot. 2004, 55, 475–483. [Google Scholar] [CrossRef] [PubMed]
- Kokkinidis, M.; Glykos, N.M.; Fadouloglou, V.E. Catalytic activity regulation through post-translational modification: The expanding universe of protein diversity. Adv. Protein Chem. Struct. Biol. 2020, 122, 97–125. [Google Scholar] [CrossRef]
- Soares, C.; Carvalho, M.E.; Azevedo, R.A.; Fidalgo, F. Plants facing oxidative challenges—A little help from the antioxidant networks. Environ. Exp. Bot. 2019, 161, 4–25. [Google Scholar] [CrossRef]
- Ivankov, A.; Nauciene, Z.; Zukiene, R.; Degutyte-Fomins, L.; Malakauskiene, A.; Kraujalis, P.; Venskutonis, P.R.; Filatova, I.; Lyushkevich, V.; Mildaziene, V. Changes in growth and production of non-psychotropic cannabinoids induced by pre-sowing treatment of hemp seeds with cold plasma, vacuum and electromagnetic field. Appl. Sci. 2020, 10, 8519. [Google Scholar] [CrossRef]
- Mildaziene, V.; Pauzaite, G.; Nauciene, Z.; Zukiene, R.; Malakauskiene, A.; Norkeviciene, E.; Stukonis, V.; Slepetiene, A.; Olsauskaite, V.; Padarauskas, A.; et al. Effect of seed treatment with cold plasma and electromagnetic field on red clover germination, growth and content of major isoflavones. J. Phys. D Appl. Phys. 2020, 53, 264001. [Google Scholar] [CrossRef]
- Ivankov, A.; Zukiene, R.; Nauciene, Z.; Degutyte-Fomins, L.; Filatova, I.; Lyushkevich, V.; Mildaziene, V. The effects of red clover seed treatment with cold plasma and electromagnetic field on germination and seedling growth are dependent on seed color. Appl. Sci. 2021, 11, 4676. [Google Scholar] [CrossRef]
- Judickaitė, A.; Lyushkevich, V.; Filatova, I.; Mildažienė, V.; Žūkienė, R. The potential of cold plasma and electromagnetic field as stimulators of natural sweeteners biosynthesis in Stevia rebaudiana Bertoni. Plants 2022, 11, 611. [Google Scholar] [CrossRef]
- Pérez-Alonso, N.; Jiménez, E. Producción de metabolitos secundarios de plantas mediante el cultivo in vitro. Biotechnol. Veg. 2011, 11, 195–211. [Google Scholar]
- McDonald, K.A.; Jackman, A.P.; Thorup, J.E.; Dandekar, A.M. Plant callus as a source of biochemicals. Appl. Biochem. Biotechnol. 1995, 54, 93–108. [Google Scholar] [CrossRef]
- Al-Khalil, S.; Tosa, H.; Iinuma, M. A xanthone C-glycoside from Iris nigricans. Phytochemistry 1995, 38, 729–731. [Google Scholar] [CrossRef]
- Razdan, T.K.; Kachroo, P.K.; Qadri, B.; Kalla, A.K.; Taneja, S.C.; Koul, S.K.; Dhar, K.L. Isocladrastin and kashmigenin—Two isoflavones from Iris kashmiriana. Phytochemistry 1996, 41, 947–949. [Google Scholar] [CrossRef]
- Zhang, X.; Qiao, G.-X.; Zhao, G.-F.; Zhao, S.-F. Characterization of the metabolites of irisflorentin by using ultra-high performance liquid chromatography combined with quadrupole/orbitrap tandem mass spectrometry. J. Pharm. Biomed. Anal. 2021, 203, 114222. [Google Scholar] [CrossRef]
- Fang, R.; Veitch, N.C.; Kite, G.C.; Howes, M.J.R.; Porter, E.A.; Simmonds, M.S. Glycosylated Constituents of Iris fulva and Iris brevicaulis. Chem. Pharm. Bull. 2011, 59, 124–128. [Google Scholar] [CrossRef]
- Yehia, S.M.; Ayoub, I.M.; Watanabe, M.; Devkota H., P.; Singab, A.N.B. Metabolic profiling, antioxidant, and enzyme inhibition potential of Iris pseudacorus L. from Egypt and Japan: A comparative study. Sci. Rep. 2023, 13, 5233. [Google Scholar] [CrossRef]
- Song, Y.Y.; Liu, Y.; Yan, Y.M.; Lu, X.F.; Cheng, Y.X. Phenolic compounds from Belamcanda chinensis seeds. Molecules 2018, 23, 580. [Google Scholar] [CrossRef]
- Roger, B.; Jeannot, V.; Fernandez, X.; Cerantola, S.; Chahboun, J. Characterisation and quantification of flavonoids in Iris germanica L. and Iris pallida Lam. resinoids from Morocco. Phytochem. Anal. 2012, 23, 450–455. [Google Scholar] [CrossRef]
- Salehi, B.; Venditti, A.; Sharifi-Rad, M.; Kregiel, D.; Sharifi-Rad, J.; Durazzo, A.; Lucarini, M.; Santini, A.; Souto, E.B.; Novellino, E.; et al. The therapeutic potential of apigenin. Int. J. Mol. Sci. 2019, 20, 1305. [Google Scholar] [CrossRef]
- Chen, K.; Gao, Z. Acacetin, a Natural Flavone with Potential in Improving Liver Disease Based on Its Anti-Inflammation, Anti-Cancer, Anti-Infection and Other Effects. Molecules 2024, 29, 4872. [Google Scholar] [CrossRef] [PubMed]
- Pashaei, R. Features of Apigenin, Luteolin, Hesperetin and Naringenin in Crop and Body. Int. J. Food Sci. Nutr. Diet. 2016, 5, 300–304. [Google Scholar] [CrossRef]
- Moghaddam, H.R.; Samimi, Z.; Zachariah Moradi, S.; Little, P.J.; Xu, S.; Farzaei, M.H. Naringenin and naringin in cardiovascular disease prevention: A preclinical review. Eur. J. Pharmacol. 2020, 887, 173535. [Google Scholar] [CrossRef] [PubMed]
- Amin, H.I.M.; Hussain, F.H.S.; Najmaldin, S.K.; Thu, Z.M.; Ibrahim, M.F.; Gilardoni, G.; Vidari, G. Phytochemistry and Biological Activities of Iris Species Growing in Iraqi Kurdistan and Phenolic Constituents of the Traditional Plant Iris postii. Molecules 2021, 26, 264. [Google Scholar] [CrossRef]
- Alperth, F.; Mitić, B.; Mayer, S.; Maleš, Ž.; Kunert, O.; Hruševar, D.; Bucar, F. Metabolic profiling of rhizomes of native populations of the strictly endemic Croatian species Iris adriatica. Plant Biosyst. 2019, 153, 317–324. [Google Scholar] [CrossRef]
- Conforti, F.; Menichini, F.; Rigano, D.; Senatore, F. Antiproliferative activity on human cancer cell lines after treatment with polyphenolic compounds isolated from Iris pseudopumila flowers and rhizomes. Z. Naturforsch C. 2009, 64, 490–494. [Google Scholar] [CrossRef]
- Lutter, S.; Schmalbach, K.; Esch, H.L.; Lehmann, L. The isoflavone irilone contributes to the estrogenic potential of dietary supplements containing red clover. Arch. Toxicol. 2014, 88, 309–321. [Google Scholar] [CrossRef]
- Kang, K.A.; Zhang, R.; Piao, M.J.; Ko, D.O.; Wang, Z.H.; Kim, B.J.; Park, J.W.; Kim, H.S.; Kim, D.H.; Hyun, J.W. Protective effect of irisolidone, a metabolite of kakkalide, against hydrogen peroxide induced cell damage via antioxidant effect. Bioorg. Med.Chem. 2008, 16, 1133–1141. [Google Scholar] [CrossRef]
- Tůmová, L.; Tůma, J. The efect of UV light on isofavonoid production in Genista tinctoria culture in vitro. Acta Physiol. Plant 2011, 33, 635–640. [Google Scholar] [CrossRef]
- Vidya, N.; Saravanan, K.; Halka, J.; Kowsalya, K.; Preetha, J.S.Y.; Gurusaravanan, P.; Radhakrishnan, R.; Nanthin, A.U.R.; Arun, M. An insight into in vitro strategies for bioproduction of isoflavones. Plant Biotechnol. Rep. 2021, 15, 717–740. [Google Scholar] [CrossRef]
- Heredia, J.B.; Cisneros-Zevallos, L. The effect of exogenous ethylene and methyl jasmonate on pal activity, phenolic profiles and antioxidant capacity of carrots (Daucus carota) under different wounding intensities. Postharvest Biol. Technol. 2009, 51, 242–249. [Google Scholar] [CrossRef]

| Plant Species | Culture Type | Compound | Elicitation | References |
|---|---|---|---|---|
| Iris atrofusca | Callus | Irones | Quinine | [49] |
| Essential oils | [68] | |||
| Iris domestica | Callus | Isoflavonoids | CuCl2 | [71] |
| Iris ensata | Callus | Flavonoids | [60] | |
| Flavones | [61] | |||
| Iris germanica | Root cultures | Isoflavonoids | CuCl2 | [62] |
| Callus | Carotenoids | [73] | ||
| Iris pallida | Cell suspensions | Iridals | [66] | |
| Leaves | [59] | |||
| Iris petrana | Callus | Irones | Quinine | [49] |
| Essential oils | [68] | |||
| Iris pseudacorus | Cell suspensions | Iridals | [67] | |
| Callus | Isoflavonoids | Phenilalanine | [70] | |
| Shoots, roots | Phenolics | Jasmonic acid | [72] | |
| Root culture | Isoflavones | [64] | ||
| Iris reichenbachii | Callus, Shoots | Xanthone (Mangiferin) | [69] | |
| Iris sibirica | Callus | γ irone | [65] | |
| Cell suspension | Volatile oils | [74] | ||
| Shoots | Flavonoids | Auxin (NAA) | [75] | |
| Isoflavonoids | [63] | |||
| Mangiferin | [76] |
| No | Compound name | tR * (min) | Molecular Formula [M–H]– | Calculated Mass [M–H]– | Exact Mass [M–H]– | Δ ppm | NEC ** | PLASMA | EC | ||
|---|---|---|---|---|---|---|---|---|---|---|---|
| 1W | 3W | 1Y | |||||||||
| Flavonoids and derivatives | |||||||||||
| 1 | Apigenin 6-C-hexoside-8-C-pentoside | 5.91 | C26H27O14− | 563,14063 | 563,13940 | 2.18 | + | + | + | − | − |
| 2 | Naringenin | 9.46 | C15H11O5− | 271,06120 | 271,06000 | 4.43 | − | + | + | + | − |
| 3 | Apigenin | 9.49 | C15H9O5− | 269,04554 | 269,0,474 | 2.97 | − | + | + | + | − |
| 4 | Acacetin | 11.80 | C16H11O5– | 283,06119 | 283,06110 | 0.32 | − | + | + | + | − |
| Isoflavone glycosides | |||||||||||
| 5 | Tectoridin (Tectorigenin 7-O-hexoside) | 5.93 | C22H21O11– | 461,10894 | 461,10894 | −0.01 | + | + | + | − | + |
| 6 | Iristectorin B (Iristectorigenin B 7-O-hexoside) | 6.14 | C23H23O12– | 491,11950 | 491,11961 | −0.23 | + | + | + | − | + |
| 7 | Irislactin A | 6.21 | C40H47O22– | 879,25645 | 879,25719 | −0.84 | − | − | − | − | + |
| 8 | Acetylated sucrose derivative 1 | 6.26 | C41H49O23– | 909,26701 | 909,26698 | 0.04 | − | − | − | − | + |
| 9 | Isotectorigenin 7-O-hexoside | 6.37 | C22H21O11– | 461,10894 | 461,10919 | −0.55 | − | − | − | − | + |
| 10 | Iridin (Irigenin 7-O-hexoside) | 6.42 | C24H25O13– | 521,13007 | 521,13006 | 0.01 | + | + | + | − | + |
| 11 | Homotectoridin (Homotectorigenin 7-O-glucoside) | 6.52 | C23H23O12– | 491,11950 | 491,11987 | −0.75 | − | − | − | − | + |
| 12 | Isoridin (Isoirigenin 7-O-hexoside) | 6.82 | C24H25O13– | 521,13007 | 521,13007 | 0.00 | − | − | − | − | + |
| 13 | Acetylated sucrose derivative 2 | 7.05 | C45H53O25– | 993,28814 | 993,28742 | 0.73 | − | − | − | − | + |
| 14 | Iristectorin A (Iristectorigenin A 7-O-hexoside) | 7.27 | C23H23O12– | 491,11950 | 491.11764 | 3.79 | + | + | + | − | + |
| 15 | Iridin S (Irisjaponin B 7-O-hexoside) | 7.34 | C25H27O13– | 535,14572 | 535.14559 | 0.24 | + | + | + | − | + |
| 16 | Irisolone 4′-O-(6′′-rhamnosyl)-hexoside | 7.52 | C29H31O15– | 619,16684 | 619,16681 | 0.05 | + | − | − | − | − |
| 17 | Irilone 4′-O-(6′′-hexosyl)-hexoside | 7.54 | C28H29O16– | 621,14611 | 621,14423 | 3.03 | − | − | − | − | − |
| 18 | Iriflogenin 4′-O-(6′′-hexosyl)-hexoside | 7.60 | C29H31O17− | 651,15667 | 651,15625 | 0.65 | + | − | − | − | − |
| 19 | Acetylated sucrose derivative 3 | 7.87 | C46H53O25– | 1005,28,814 | 1005,28768 | 0.46 | − | − | − | − | + |
| 20 | Iristectorigenin A/B 7-O-(acetyl)hexoside | 7.88 | C25H25O13− | 533,13006 | 533,13006 | 0.00 | + | + | + | − | − |
| 21 | Acetylated sucrose derivative 4 | 7.90 | C47H55O26– | 1035,29871 | 1035,29881 | −0.10 | − | − | − | − | + |
| 22 | Irisolone 4′-O-[6′′-(3-hydroxy-3-methylglutaryl)]-hexoside | 8.30 | C29H29O15– | 617,15119 | 617,15070 | 0.79 | + | + | + | − | − |
| 23 | Iriskashmirianin 4′-O-[6′′-(3-hydroxy-3-methylglutaryl)]-hexoside | 8.32 | C30H31O16– | 647,16176 | 647,16138 | 0.59 | + | + | + | − | − |
| 24 | Iriflogenin 4′-O-[6′′-(3-hydroxy-3-methylglutaryl)]-hexoside | 8.90 | C29H29O16– | 633,14611 | 633,14349 | 4.14 | + | + | + | − | − |
| Isoflavone aglycones | |||||||||||
| 25 | Iristectorigenin A | 6.34 | C17H13O7– | 329,06668 | 329,06688 | −0.62 | − | − | − | − | + |
| 26 | 5,7,4′-Trihydroxy-6,3′,5′-trimethoxyisoflavone | 6.47 | C18H15O8– | 359,07724 | 359,07718 | 0.17 | − | − | − | − | + |
| 27 | Irisolone | 7.71 | C17H11O6– | 311,05611 | 311,05545 | 2.12 | + | + | + | − | − |
| 28 | Noririsflorentin | 7.88 | C19H15O8– | 371,07724 | 371,07657 | 1.81 | + | + | + | − | − |
| 29 | Tectorigenin | 8.01 | C16H11O6– | 299,05611 | 299,05605 | 0.20 | + | + | + | − | + |
| 30 | Dalspinosin | 8.17 | C18H15O7– | 343,308233 | 343,08127 | 3.09 | + | + | + | − | − |
| 31 | Iristectorigenin B | 8.19 | C17H13O7– | 329,06668 | 329,06667 | 0.02 | − | − | − | − | + |
| 32 | Irigenin | 8.33 | C18H15O8– | 359,07724 | 359,07715 | 0.24 | + | + | + | + | + |
| 33 | 8-Hydroxyirigenin | 8.33 | C18H15O9– | 375,07216 | 375,07214 | 0.05 | − | − | − | − | + |
| 34 | Iristectorigenin A/B | 9.93 | C17H13O7− | 329,06668 | 329,06592 | 2.31 | + | + | + | + | + |
| 35 | Isoirigenin | 9.97 | C18H15O8– | 359,07724 | 359,07731 | −0.18 | − | − | − | − | + |
| 36 | Irisolidone | 10.89 | C17H13O6− | 313,07176 | 313,07166 | 0.32 | − | + | + | + | − |
| 37 | Irilone | 11.19 | C16H9O6− | 297,04046 | 297,04046 | 0.00 | − | + | + | + | − |
| Other compounds | |||||||||||
| 38 | Diferuloylsucrose | 6.04 | C32H37O17– | 69,320,362 | 69,320,357 | 0.07 | − | − | − | − | + |
| 39 | Shegansu C | 8.19 | C44H47O21– | 91,126,153 | 91,126,037 | 1.28 | − | − | − | − | + |
| 40 | Shegansu C isomer | 8.47 | C44H47O21– | 91,126,153 | 91,126,104 | 0.55 | − | − | − | − | + |
Disclaimer/Publisher’s Note: The statements, opinions and data contained in all publications are solely those of the individual author(s) and contributor(s) and not of MDPI and/or the editor(s). MDPI and/or the editor(s) disclaim responsibility for any injury to people or property resulting from any ideas, methods, instructions or products referred to in the content. |
© 2025 by the authors. Licensee MDPI, Basel, Switzerland. This article is an open access article distributed under the terms and conditions of the Creative Commons Attribution (CC BY) license (https://creativecommons.org/licenses/by/4.0/).
Share and Cite
Jevremović, S.; Milutinović, M.; Veličković, K.; Gašić, U.; Škoro, N.; Puač, N.; Živković, S. Cold Plasma Treatment Alters the Morphology, Oxidative Stress Response and Specialized Metabolite Content in Yellow Iris (I. reichenbachii) Callus. Horticulturae 2025, 11, 781. https://doi.org/10.3390/horticulturae11070781
Jevremović S, Milutinović M, Veličković K, Gašić U, Škoro N, Puač N, Živković S. Cold Plasma Treatment Alters the Morphology, Oxidative Stress Response and Specialized Metabolite Content in Yellow Iris (I. reichenbachii) Callus. Horticulturae. 2025; 11(7):781. https://doi.org/10.3390/horticulturae11070781
Chicago/Turabian StyleJevremović, Slađana, Milica Milutinović, Ksenija Veličković, Uroš Gašić, Nikola Škoro, Nevena Puač, and Suzana Živković. 2025. "Cold Plasma Treatment Alters the Morphology, Oxidative Stress Response and Specialized Metabolite Content in Yellow Iris (I. reichenbachii) Callus" Horticulturae 11, no. 7: 781. https://doi.org/10.3390/horticulturae11070781
APA StyleJevremović, S., Milutinović, M., Veličković, K., Gašić, U., Škoro, N., Puač, N., & Živković, S. (2025). Cold Plasma Treatment Alters the Morphology, Oxidative Stress Response and Specialized Metabolite Content in Yellow Iris (I. reichenbachii) Callus. Horticulturae, 11(7), 781. https://doi.org/10.3390/horticulturae11070781

